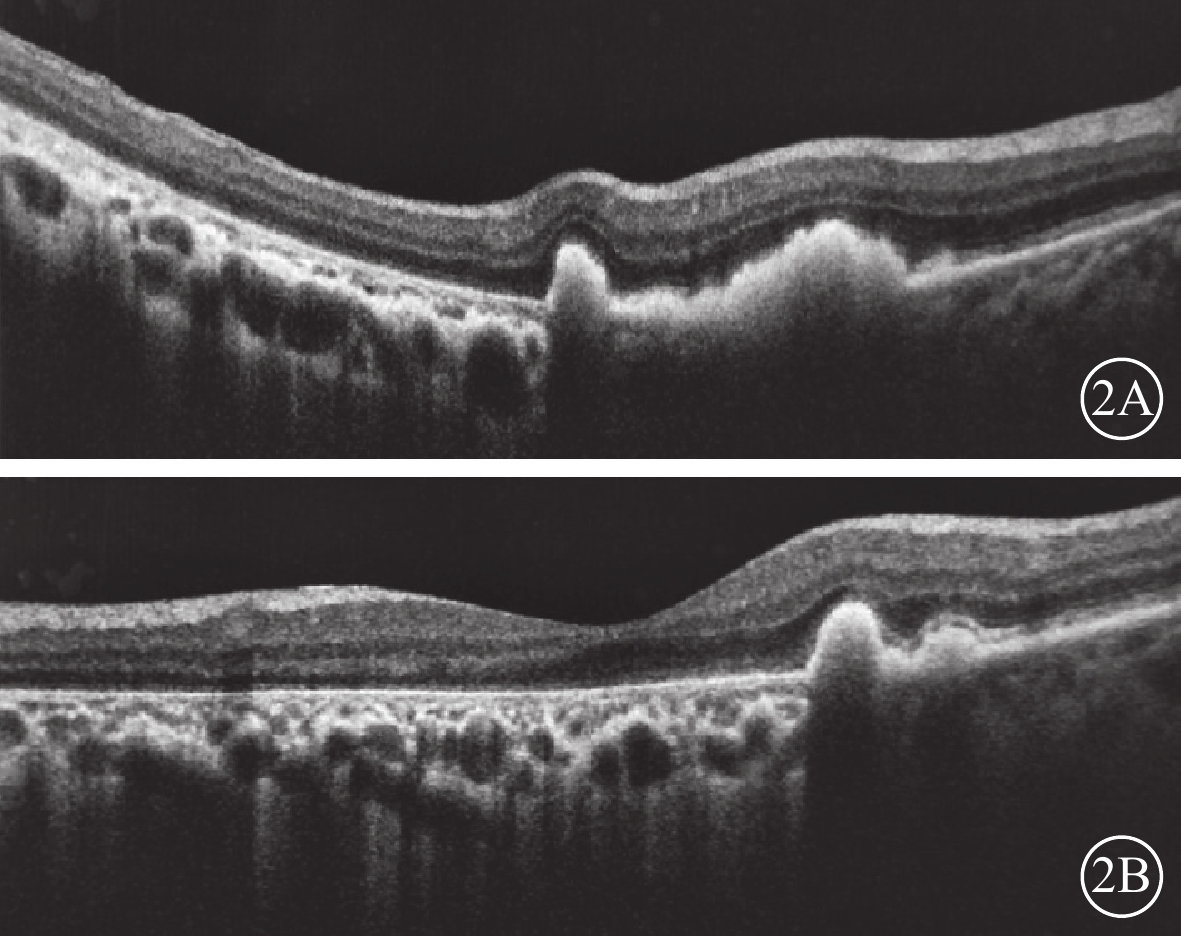

引用本文: 常魯華, 薛憲華, 劉愛英, 王景艷, 王迎開. 特發性雙眼視網膜色素上皮撕裂及光相干斷層掃描影像觀察一例. 中華眼底病雜志, 2019, 35(4): 390-390. doi: 10.3760/cma.j.issn.1005-1015.2019.04.016 復制
患者女,68歲。因雙眼視物模糊20 d于2018年3月20日來我院眼科就診。既往肺心病10年;否認雙眼外傷史,否認遺傳病家族史。眼部檢查:雙眼視力0.1,均不能矯正。右眼眼壓16 mmHg(1 mmHg=0.133 kPa),左眼眼壓15 mmHg。雙眼眼前節檢查正常。眼底檢查,雙眼后極部巨大RPE撕裂,撕裂區透見脈絡膜水腫;上方RPE收縮卷曲皺褶;視網膜血管紆曲(圖1)。OCT檢查,后極部撕裂區RPE信號消失。對應RPE卷曲皺褶處強反射隆起信號。未撕裂范圍RPE信號正常(圖2)。因患者原因未行FFA檢查。臨床診斷:雙眼特發性RPE撕裂。
 圖1
雙眼彩色眼底像。1A示右眼,后極部巨大不規則形RPE撕裂,上方可見皺褶隆起。隆起處視網膜血管呈爬坡樣;1B示左眼,后極部半月形撕裂區,上方RPE收縮卷曲,視網膜小靜脈有毛刷樣出血
圖1
雙眼彩色眼底像。1A示右眼,后極部巨大不規則形RPE撕裂,上方可見皺褶隆起。隆起處視網膜血管呈爬坡樣;1B示左眼,后極部半月形撕裂區,上方RPE收縮卷曲,視網膜小靜脈有毛刷樣出血
 圖2
雙眼OCT像。2A示右眼,卷曲的RPE呈隆起性強反射信號;2B示左眼,黃斑撕裂區RPE信號消失,脈絡膜水腫
圖2
雙眼OCT像。2A示右眼,卷曲的RPE呈隆起性強反射信號;2B示左眼,黃斑撕裂區RPE信號消失,脈絡膜水腫
討論 當脈絡膜流體靜壓超過RPE與Bruch膜粘附的力量,即發生RPE脫離[1]。理論上各種可以引起RPE脫離的眼底疾病均有導致RPE撕裂的可能,但臨床上并不多見[2-4]。于珊珊等[3]將息肉樣脈絡膜病變致RPE撕裂的撕裂區位置以血管弓為界,分為血管弓內、血管弓上、血管弓外,并根據撕裂區的形狀分為新月形、半月形和不規則形。RPE的撕裂一般由RPE脫離自發形成。常見于滲出型老年性黃斑變性引起的纖維素性RPE脫離、息肉樣脈絡膜病變引起的出血性或漿液性RPE脫離,也可發生于光動力療法、玻璃體腔注射抗VEGF藥物以及激光光凝治療后[4]。本例患者雙眼巨大RPE撕裂臨床較為少見。因患者未行FFA檢查,RPE撕裂的原因不排除上述病因。但如此巨大的撕裂或許可能與患者存在肺心病史,體循環淤血,脈絡膜靜脈回流阻力增大有關。RPE細胞間的連接在流體靜壓的作用下發生斷裂。如果壓力足夠大,是否會產生“爆破”現象,繼而發生巨大撕裂。從裂開處RPE向一側收縮卷曲,撕裂區暴露水腫的脈絡膜。RPE撕裂是否也為肺心病的眼部并發癥值得進一步研究探討。
患者女,68歲。因雙眼視物模糊20 d于2018年3月20日來我院眼科就診。既往肺心病10年;否認雙眼外傷史,否認遺傳病家族史。眼部檢查:雙眼視力0.1,均不能矯正。右眼眼壓16 mmHg(1 mmHg=0.133 kPa),左眼眼壓15 mmHg。雙眼眼前節檢查正常。眼底檢查,雙眼后極部巨大RPE撕裂,撕裂區透見脈絡膜水腫;上方RPE收縮卷曲皺褶;視網膜血管紆曲(圖1)。OCT檢查,后極部撕裂區RPE信號消失。對應RPE卷曲皺褶處強反射隆起信號。未撕裂范圍RPE信號正常(圖2)。因患者原因未行FFA檢查。臨床診斷:雙眼特發性RPE撕裂。
 圖1
雙眼彩色眼底像。1A示右眼,后極部巨大不規則形RPE撕裂,上方可見皺褶隆起。隆起處視網膜血管呈爬坡樣;1B示左眼,后極部半月形撕裂區,上方RPE收縮卷曲,視網膜小靜脈有毛刷樣出血
圖1
雙眼彩色眼底像。1A示右眼,后極部巨大不規則形RPE撕裂,上方可見皺褶隆起。隆起處視網膜血管呈爬坡樣;1B示左眼,后極部半月形撕裂區,上方RPE收縮卷曲,視網膜小靜脈有毛刷樣出血
 圖2
雙眼OCT像。2A示右眼,卷曲的RPE呈隆起性強反射信號;2B示左眼,黃斑撕裂區RPE信號消失,脈絡膜水腫
圖2
雙眼OCT像。2A示右眼,卷曲的RPE呈隆起性強反射信號;2B示左眼,黃斑撕裂區RPE信號消失,脈絡膜水腫
討論 當脈絡膜流體靜壓超過RPE與Bruch膜粘附的力量,即發生RPE脫離[1]。理論上各種可以引起RPE脫離的眼底疾病均有導致RPE撕裂的可能,但臨床上并不多見[2-4]。于珊珊等[3]將息肉樣脈絡膜病變致RPE撕裂的撕裂區位置以血管弓為界,分為血管弓內、血管弓上、血管弓外,并根據撕裂區的形狀分為新月形、半月形和不規則形。RPE的撕裂一般由RPE脫離自發形成。常見于滲出型老年性黃斑變性引起的纖維素性RPE脫離、息肉樣脈絡膜病變引起的出血性或漿液性RPE脫離,也可發生于光動力療法、玻璃體腔注射抗VEGF藥物以及激光光凝治療后[4]。本例患者雙眼巨大RPE撕裂臨床較為少見。因患者未行FFA檢查,RPE撕裂的原因不排除上述病因。但如此巨大的撕裂或許可能與患者存在肺心病史,體循環淤血,脈絡膜靜脈回流阻力增大有關。RPE細胞間的連接在流體靜壓的作用下發生斷裂。如果壓力足夠大,是否會產生“爆破”現象,繼而發生巨大撕裂。從裂開處RPE向一側收縮卷曲,撕裂區暴露水腫的脈絡膜。RPE撕裂是否也為肺心病的眼部并發癥值得進一步研究探討。